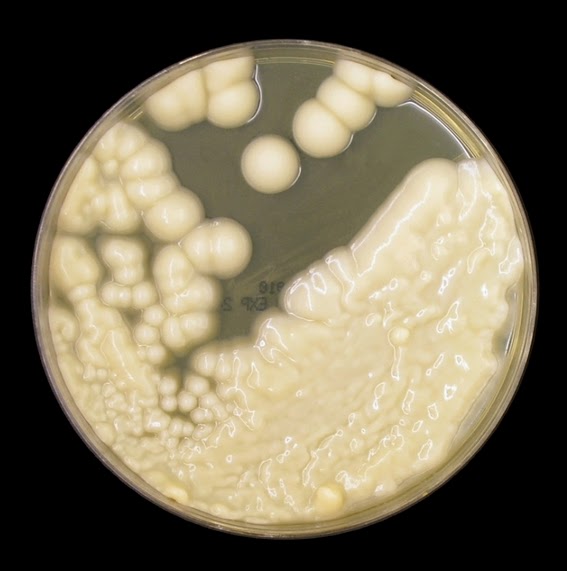

Изящество микромира: Arthrobotrys oligospora на макроснимке

Раздел: Природная галерея